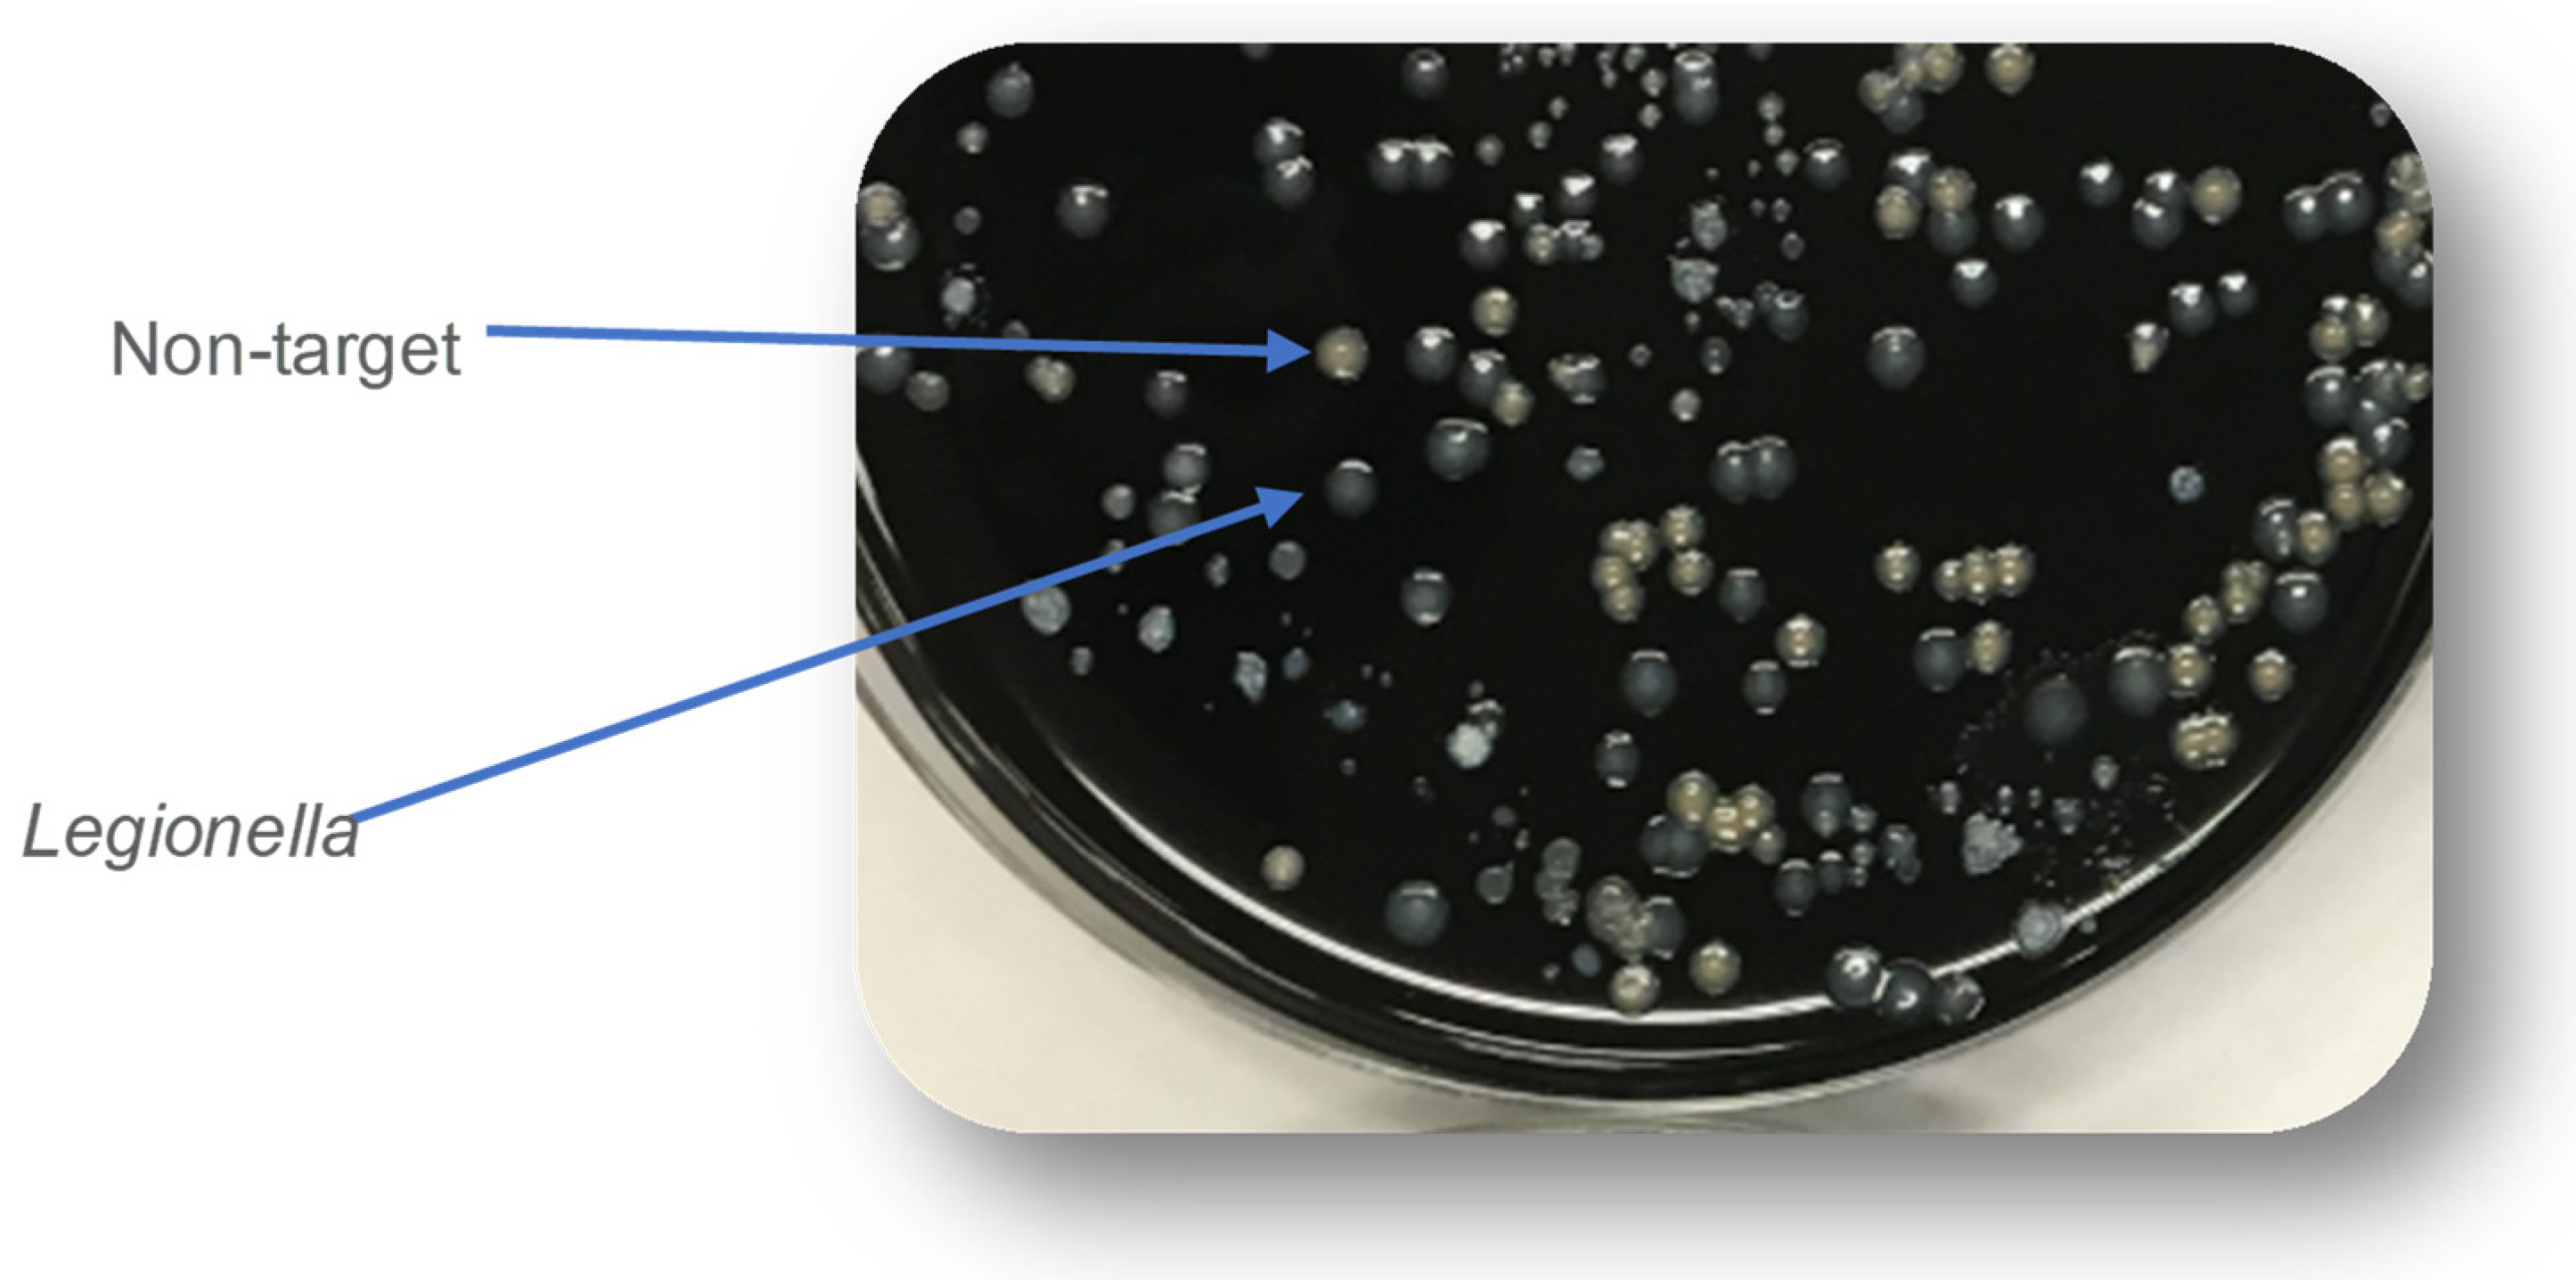
Water 17 00475 g004 Water 17 00475 g004

The Case for Monitoring for Legionella pneumophila in Drinking Water Distribution Systems
Abstract
1. Introduction
2. Legionella Overview
3. Methods for Legionella Detection
4. Guidelines for Legionella Management
- (a)
- “No additional monitoring” for environmental surveillance and control;
- (b)
- “Monitor and control all Legionella pneumophila” strategy; and
- (c)
- “Monitor and control Legionella species” strategy.
5. Conclusions
- For both community-acquired and healthcare-associated Legionnaires’ disease, L. pneumophila is the overwhelming cause of illness. Waterborne illnesses due to non-pneumophila species of Legionella are rare particularly outside clinical environments.
- Although less well studied, cases of Pontiac fever have not followed the same 20-year trend in increases in cases of Legionnaires’ disease. Most cases of Pontiac fever are associated with non-potable sources of water.
- The concentration or occurrence of Legionella species has not been shown to be a reliable predictor of L. pneumophila, and the health impacts of Legionella species are low relative to L. pneumophila. Treating counts of L. pneumophila and non-pneumophila species equally is without any scientific basis and results in unnecessary cost with little public health benefit.
- Careful consideration must be taken when selecting an appropriate method for monitoring Legionella in water systems. There are many alternatives to the ISO 11731:2017 that are easier to use and provide more accurate analyses. Although molecular methods hold the promise of more rapid analyses, the commercial kits require additional validation, and viability analyses need more research. The Legiolert test has proven to be simple, accurate, and feasible for use by water utilities.
- Although a challenge, it would be useful to develop quantitative risk assessments for L. pneumophila and non-pneumophila species in water.
- Countries continue to determine how to focus their guidelines and whether they should promote the routine monitoring and control of Legionella species and/or L. pneumophila. One option would be to consider water in clinically significant settings differently from distribution systems or non-healthcare buildings. It is prudent to hold healthcare facilities to a higher water quality standard than potable water systems or public buildings when severely immunocompromised patients may be present.
Funding
Data Availability Statement
Acknowledgments
Conflicts of Interest
References
- National Academies of Sciences, Engineering, and Medicine (NASEM). Management of Legionella in Water Systems; The National Academies Press: Washington, DC, USA, 2019. [Google Scholar] [CrossRef]
- Khodr, A.; Kay, E.; Gomez-Valero, L.; Ginevra, C.; Doublet, P.; Buchrieser, C.; Jarraud, S. Molecular epidemiology, phylogeny, and evolution of Legionella. Infect. Genet. Evol. 2016, 43, 108–122. [Google Scholar] [CrossRef]
- Vaccaro, L.; Izquierdo, F.; Magnet, A.; Hurtado, C.; Salinas, M.A.; Gomes, T.S.; Angulo, S.; Salso, S.; Pelaez, J.; Tejeda, M.I.; et al. First case of Legionnaire’s disease caused by Legionella anisa in Spain and the limitations on the diagnosis of Legionella non-pneumophila infections. PLoS ONE 2016, 11, e016293. [Google Scholar]
- Fields, B.S.; Benson, R.F.; Besser, R.E. Legionella and Legionnaires’ Disease: 25 Years of Investigation. Clin. Microbiol. Rev. 2002, 15, 506–526. [Google Scholar] [CrossRef]
- Beauté, J.; Plachouras, D.; Sandin, S.; Giesecke, J.; Sparén, P. Healthcare-Associated Legionnaires’ Disease, Europe, 2008–2017. Emerg. Infect. Dis. 2020, 26, 2309–2318. [Google Scholar] [CrossRef]
- Cross, K.E.; Mercante, J.W.; Benitez, A.J.; Brown, E.W.; Diaz, M.H.; Winchell, J.M. Simultaneous detection of Legionella species and L. anisa, L. bozemanii, L. longbeachae, and L. micdadei using conserved primers and multiple probes in a multiplex real-time PCR assay. Diagn. Microbiol. Infect. Dis. 2016, 85, 295–301. [Google Scholar] [CrossRef] [PubMed][Green Version]
- Dooling, K.L.; Toews, K.A.; Hicks, L.A.; Garrison, L.E.; Bachaus, B.; Zansky, S.; Carpenter, L.R.; Schaffner, B.; Parker, E.; Petit, S.; et al. Active bacterial core surveillance for Legionellosis—United States, 2011–2013. Morb. Mortal. Wkly. Rep. 2013, 64, 1190–1193. [Google Scholar] [CrossRef]
- von Baum, H.; Ewig, S.; Marre, R.; Suttorp, N.; Gonschior, S.; Welte, T.; Lück, C. Community-acquired Legionella pneumonia: New insights from the German competence network for community acquired pneumonia. Clin. Infect. Dis. 2008, 46, 1356–1364. [Google Scholar] [CrossRef]
- Yu, V.L.; Plouffe, J.F.; Pastoris, M.C.; Stout, J.E.; Schousboe, M.; Widmer, A.; Summersgill, J.; File, T.; Heath, C.M.; Paterson, D.L.; et al. Distribution of Legionella species and serogroups isolated by culture in patients with sporadic community-acquired legionellosis: An international collaborative survey. J. Infect. Dis. 2002, 186, 127–128. [Google Scholar] [CrossRef] [PubMed]
- Collier, S.A.; Deng, L.; Adam, E.A.; Benedict, K.M.; Beshearse, E.M.; Blackstock, A.J.; Bruce, B.B.; Derado, G.; Edens, C.; Fullerton, K.E.; et al. Estimate of Burden and Direct Healthcare Cost of Infectious Waterborne Disease in the United States. Emerg. Infect. Dis. 2021, 27, 140–149. [Google Scholar] [CrossRef]
- European Centre for Disease Prevention and Control (ECDC). Legionnaires’ Disease. 2025. Available online: https://www.ecdc.europa.eu/en/legionnaires-disease (accessed on 25 January 2025).
- Whiley, H.; Bentham, R. Legionella longbeachae and legionellosis. Emerg. Infect. Dis. 2011, 17, 579–583. [Google Scholar] [CrossRef] [PubMed]
- Chambers, S.T.; Slow, S.; Scott-Thomas, A.; Murdoch, D.R. Legionellosis caused by non-Legionella pneumophila species, with a focus on Legionella longbeachae. Microorganisms 2021, 9, 291. [Google Scholar] [CrossRef] [PubMed]
- Miyashita, N.; Higa, F.; Aoki, Y.; Kikuchi, T.; Seki, M.; Tateda, K.; Maki, N.; Uchino, K.; Ogasawara, K.; Kiyota, H.; et al. Distribution of Legionella species and serogroups in patients with culture-confirmed Legionella pneumonia. J. Infect. Chemother. 2020, 26, 411–417. [Google Scholar] [CrossRef]
- Spica, V.R.; Borella, P.; Bruno, A.; Carboni, C.; Exner, M.; Hartemann, P.; Gianfranceschi, G.; Laganà, P.; Mansi, A.; Montagna, M.T.; et al. Legionnaires’ Disease Surveillance and Public Health Policies in Italy: A Mathematical Model for Assessing Prevention Strategies. Water 2024, 16, 2167. [Google Scholar] [CrossRef]
- Centers for Disease Control and Prevention (CDC). BEAM (Bacteria, Enterics, Amoeba, and Mycotics) Dashboard; Department of Health and Human Services: Atlanta, GA, USA, 2025. Available online: https://www.cdc.gov/ncezid/dfwed/BEAM-dashboard.html (accessed on 13 January 2025).
- Kunz, J.M.; Lawinger, H.; Miko, S.; Gerdes, M.; Thuneibat, M.; Hannapel, E.; Roberts, V.A. Surveillance of Waterborne Disease Outbreaks Associated with Drinking Water—United States, 2015–2020. MMWR Surveill. Summ. 2024, 73, 1–23. [Google Scholar] [CrossRef] [PubMed]
- Hammes, F. Elswater Environmental Services. Legionnaires disease data as of August 20, 2024. 2024. Available online: https://www.facebook.com/photo?fbid=445277115178409&set=a.114102304962560 (accessed on 30 December 2024).
- Holsinger, H.; Tucker, N.; Regli, S.; Studer, K.; Roberts, V.A.; Collier, S.; Hannapel, E.; Edens, C.; Yoder, J.S.; Rotert, K. Characterization of reported legionellosis outbreaks associated with buildings served by public drinking water systems: United States, 2001–2017. J. Water Health 2022, 20, 702–711. [Google Scholar] [CrossRef] [PubMed]
- Benedict, K.M.; Reses, H.; Vigar, M.; Roth, D.M.; Roberts, V.A.; Mattioli, M.; Cooley, L.A.; Hilborn, E.D.; Wade, T.J.; Fullerton, K.E.; et al. Surveillance for waterborne disease outbreaks associated with drinking water—United States, 2013–2014. Morb. Mortal. Wkly. Rep. 2017, 66, 1216. [Google Scholar] [CrossRef]
- Hamilton, K.A.; Prussin, A.J.; Ahmed, W.; Haas, C.N. Outbreaks of Legionnaires’ Disease and Pontiac Fever 2006–2017. Curr. Environ. Health Rep. 2018, 5, 263–271. [Google Scholar] [CrossRef]
- Fields, B.S.; Barbaree, J.M.; Sanden, G.N.; Morrill, W.E. Virulence of a Legionella anisa strain associated with Pontiac fever: An evaluation using protozoan, cell culture, and guinea pig models. Infect. Immun. 1990, 58, 3139–3142. [Google Scholar] [CrossRef] [PubMed]
- Garrison, L.E.; Kunz, J.M.; Cooley, L.A.; Moore, M.R.; Lucas, C.; Schrag, S.; Sarisky, J.; Whitney, C.G. Vital Signs: Deficiencies in Environmental Control Identified in Outbreaks of Legionnaires’ Disease—North America, 2000–2014. Mmwr-Morb. Mortal. Wkly. Rep. 2016, 65, 576–584. [Google Scholar] [CrossRef]
- Muder, R.R.; Yu, V.L. Infection due to Legionella species other than L. pneumophila. Clin. Infect. Dis. 2002, 35, 990–998. [Google Scholar] [CrossRef]
- Gonçalves, I.G.; Fernandes, H.S.; Melo, A.; Sousa, S.F.; Simoes, L.C.; Simoes, M. LegionellaDB–a database on legionella outbreaks. Trends Microbiol. 2021, 29, 863–866. [Google Scholar] [CrossRef]
- LegionellaDB. LegionellaDB, A Database on Legionella Outbreaks. 2024. Available online: https://legionelladb.biosim.pt/ (accessed on 30 December 2024).
- ISO 11731:2017; Water Quality—Enumeration of Legionella. International Organization for Standardization (ISO): Geneva, Switzerland, 2017. Available online: https://www.iso.org/standard/61782.html (accessed on 12 December 2024).
- Lee, T.C.; Vickers, R.M.; Yu, V.L.; Wagener, M.M. Wagener. Growth of 28 Legionella Species on Selective Culture Media: A Comparative Study. J. Clin. Microbiol. 1993, 31, 2764–2768. [Google Scholar] [CrossRef]
- Luck, P.C.; Igel, L.; Helbig, J.H.; Kuhlisch, E.; Jatzwauk, L. Comparison of commercially available media for the recovery of Legionella species. Int. J. Hyg. Environ. Health 2004, 207, 589–593. [Google Scholar] [CrossRef] [PubMed]
- Sartory, D.P.; Spies, K.; Lange, B.; Schneider, S.; Langer, B. Evaluation of a most probable number method for the enumeration of Legionella pneumophila from potable and related water samples. Lett. Appl. Microbiol. 2017, 64, 271–275. [Google Scholar] [CrossRef] [PubMed]
- Spies, K.; Pleischl, S.; Lange, B.; Langer, B.; Hübner, I.; Jurzik, L.; Luden, K.; Exner, M. Comparison of the LegiolertTM/Quanti-Tray® MPN test for the enumeration of Legionella pneumophila from potable water samples with the German regulatory requirements methods ISO 11731-2 and ISO 11731. Int. J. Hyg. Environ. Health 2018, 221, 1047–1053. [Google Scholar] [CrossRef]
- Petrisek, R.; Hall, J. Evaluation of a most probable number method for the enumeration of Legionella pneumophila from North American potable and nonpotable water samples. J. Water Health 2017, 16, 25–33. [Google Scholar] [CrossRef]
- Centers for Disease Control and Prevention (CDC). Laboratory Testing for Legionella. 2024. Available online: https://www.cdc.gov/legionella/php/laboratories/index.html (accessed on 30 December 2024).
- Rech, M.M.; Swalla, B.M.; Dobranic, J.K. Evaluation of Legiolert for Quantification of Legionella pneumophila from Non-potable Water. Curr. Microbiol. 2018, 75, 1282–1289. [Google Scholar] [CrossRef]
- Barrette, I. Comparison of Legiolert and a Conventional Culture Method for Detection of Legionella pneumophila from Cooling Towers in Québec. J. AOAC Int. 2019, 102, 1235–1240. [Google Scholar] [CrossRef] [PubMed]
- Scaturro, M.; Buffoni, M.; Girolamo, A.; Cristino, S.; Girolamini, L.; Mazzotta, M.; Bucci Sabattini, M.A.; Zaccaro, C.M.; Chetti, L.; Laboratory, M.A.N. Performance of Legiolert test vs. ISO 11731 to confirm Legionella pneumophila contamination in potable water samples. Pathogens 2020, 9, 690. [Google Scholar] [CrossRef]
- Boczek, L.A.; Tang, M.; Formal, C.; Lytle, D.; Ryu, H. Comparison of two culture methods for the enumeration of Legionella pneumophila from potable water samples. J. Water Health 2021, 19, 468–477. [Google Scholar] [CrossRef] [PubMed]
- Checa, J.; Carbonell, I.; Manero, N.; Martí, I. Comparative study of Legiolert with ISO 11731-1998 standard method-conclusions from a Public Health Laboratory. J. Microbiol. Methods 2021, 186, 106242. [Google Scholar] [CrossRef]
- Dowdell, K.S.; Greenwald, H.D.; Joshi, S.; Grimard-Conea, M.; Pitell, S.; Song, Y.; Ley, C.; Kennedy, L.C.; Vosloo, S.; Huo, L. Legionella pneumophila Occurrence in Reduced-Occupancy Buildings in 11 Cities during the COVID-19 Pandemic. Environ. Sci. Water Res. Technol. 2023, 9, 2847–2865. [Google Scholar] [CrossRef]
- Hirsh, M.; Baron, J.L.; Mietzner, S.; Rihs, J.D.; Stout, J.E. Cross-reactivity of the IDEXX Legiolert Method with other Gram-negative Bacteria and Waterborne Pathogens Leads to False-Positive Assay Results. Lett. Appl. Microbiol. 2021, 72, 750–756. [Google Scholar] [CrossRef]
- Inoue, H.; Baba, M.; Tayama, S. Evaluation of Legiolert for quantification of Legionella pneumophila from bath water samples. Biocontrol Sci. 2020, 25, 179–182. [Google Scholar] [CrossRef] [PubMed]
- LeChevallier, M.W. Monitoring distribution systems for Legionella pneumophila using Legiolert. AWWA Water Sci. 2019, 1, e1122. [Google Scholar] [CrossRef]
- LeChevallier, M.W. Occurrence of culturable Legionella pneumophila in drinking water distribution systems. AWWA Wat Sci. 2019, 1, e1139. [Google Scholar] [CrossRef]
- Li, Y.; Yang, K.; Fu, L.; Gong, L.; Liu, L.; Gao, J. Comparison of the Legiolert enzyme-substrate method and the conventional cultivation for the detection of Legionella pneumophila in water samples from public places. J. Public Health Prev. Med. 2021, 6, 51–54. [Google Scholar]
- Mapili, K.; Pieper, K.J.; Dai, D.; Pruden, A.; Edwards, M.A.; Tang, M.; Rhoads, W.J. Legionella pneumophila Occurrence in Drinking Water Supplied by Private Wells. Lett. Appl. Microbiol. 2020, 70, 232–240. [Google Scholar] [CrossRef] [PubMed]
- Maqbool, A. Potential for Human Exposure to Legionella near Newtown Creek in Brooklyn, New York. Senior Projects Spring 2019. 2019. 176. Available online: https://digitalcommons.bard.edu/senproj_s2019/176 (accessed on 30 December 2024).
- McCuin, R.M.; Bartrand, T.A.; Clancy, J.L. Legionella pneumophila recovery using Legiolert and a traditional culture method. AWWA Water Sci. 2021, 3, e1228. [Google Scholar] [CrossRef]
- Niu, C.; Zhang, Y.; Zhang, Y. Evaluation of a Most Probable Number Method for Detection and Quantification of Legionella pneumophila. Pathogens 2022, 11, 789. [Google Scholar] [CrossRef]
- Omoregie, E.; Szczerba, A.; Novak, J.; Rubinstein, I.; Chuang, Y.; Wu, J.; Wang, J.; Kretz, C.; Hughes, S.; Capetanakis, A. Legionella monitoring in the New York City water distribution system 2017 to 2019. AWWA Water Sci. 2022, 4, e1272. [Google Scholar] [CrossRef]
- Dietersdorfer, E.; Kirschner, A.; Schrammel, B.; Ohradanova-Repic, A.; Stockinger, H.; Sommer, R.; Walochnik, J.; Cervero-Aragó, S. Starved viable but non-culturable (VBNC) Legionella strains can infect and replicate in amoebae and human macrophages. Water Res. 2018, 141, 428–438. [Google Scholar] [CrossRef]
- Cervero-Aragó, S.; Schrammel, B.; Dietersdorfer, E.; Sommer, R.; Lück, C.; Walochnik, J.; Kirschner, A. Viability and infectivity of viable but nonculturable Legionella pneumophila strains induced at high temperatures. Water Res. 2019, 158, 268–279. [Google Scholar] [CrossRef]
- Steinert, M.; Emödy, L.; Amann, R.; Hacker, J. Resuscitation of viable but nonculturable Legionella pneumophila Philadelphia JR32 by Acanthamoeba castellanii. Appl. Environ. Microbiol. 1997, 63, 2047–2053. [Google Scholar] [CrossRef]
- Bartrand, T.A.; LeChevallier, M.; Clancy, J.L.; Burlingame, G.; McCuin, R. Occurrence of Legionella pneumophila in Drinking Water Distribution Systems; The Water Research Foundation: Denver, CO, USA, 2024; Available online: https://www.waterrf.org/research/projects/occurrence-legionella-pneumophila-drinking-water-distribution-systems (accessed on 30 December 2024).
- Wang, H.; Edwards, M.; Falkinham, J.O.; Pruden, A. Molecular Survey of the Occurrence of Legionella spp., Mycobacterium spp., Pseudomonas aeruginosa, and Amoeba Hosts in Two Chloraminated Drinking Water Distribution Systems. Appl. Environ. Microbiol. 2012, 78, 6285–6294. [Google Scholar] [CrossRef]
- van der Lugt, W.; Euser, S.M.; Bruin, J.P.; Boer, J.W.D.; Yzerman, E.P. Wide-scale study of 206 buildings in the Netherlands from 2011 to 2015 to determine the effect of drinking water management plans on the presence of Legionella spp. Water Res. 2019, 161, 581–589. [Google Scholar] [CrossRef] [PubMed]
- Wéry, N.; Bru-Adan, V.; Minervini, C.; Delgénes, J.-P.; Garrelly, L.; Godon, J.-J. Dynamics of Legionella spp. and bacterial populations during the proliferation of L. pneumophila in a cooling tower facility. Appl. Environ. Microbiol. 2008, 74, 3030–3037. [Google Scholar] [CrossRef] [PubMed]
- American Industrial Hygiene Association (AIHA). Recognition, Evaluation, and Control of Legionella in Building Water Systems; American Industrial Hygiene Association: Falls Church, VA, USA, 2015. [Google Scholar]
- LeChevallier, M.W. Towards a More Effective Legislation for Legionella Control in Drinking Water Systems. Sent to the Dutch House of Representatives by the Minister of Infrastructure and Water Management by Letter on November 16 2021. 2021. Available online: https://open.overheid.nl/documenten/ronl-d2695abf-d88e-4e42-ad99-31d38403cdb9/pdf (accessed on 30 December 2024).
- Centers for Disease Control and Prevention (CDC). Toolkit for Controlling Legionella in Common Sources of Exposure (Legionella Control Toolkit) [WWW Document]. 2021. Available online: https://www.cdc.gov/control-legionella/media/pdfs/Control-Toolkit-All-Modules.pdf (accessed on 1 December 2024).
- American Society of Heating, Refrigerating and Air-Conditioning Engineers (ASHRAE). Standard 188 Legionellosis: Risk Management for Building Water Systems; ASHRAE: Atlanta, GA, USA, 2018. [Google Scholar]
- American Society of Heating, Refrigerating and Air-Conditioning Engineers (ASHRAE). ASHRAE Guideline 12-2020. Minimizing the Risk of Legionellosis Associated with Building Water Systems; ASHRAE: Atlanta, GA, USA, 2020. [Google Scholar]
- European Drinking Water Directive. Directive (EU) 2020/2184 of the European Parliament and of the Council of 16 December 2020 on the Quality of Water Intended for Human Consumption. 2020. Available online: https://eur-lex.europa.eu/legal-content/EN/TXT/PDF/?uri=CELEX:32020L2184 (accessed on 30 December 2024).
- Doleans, A.; Aurell, H.; Reyrolle, M.; Lina, G.; Freney, J.; Vandenesch, F.; Etienne, J.; Jarraud, S. Clinical and environmental distributions of Legionella strains in France are different. J. Clin. Microbiol. 2004, 42, 458–460. [Google Scholar] [CrossRef]
- Zacharias, N.; Waßer, F.; Freier, L.; Spies, K.; Koch, C.; Pleischl, S.; Mutters, N.T.; Kistemann, T. Legionella in drinking water: The detection method matters. J. Water Health 2023, 21, 884–894. [Google Scholar] [CrossRef] [PubMed]
- Rucinski, S.L.; Murphy, M.P.; Kies, K.D.; Cunningham, S.A.; Schuetz, A.N.; Patel, R. Eight years of clinical Legionella PCR testing illustrate seasonal patterns. Clin. Infect. Dis. 2018, 218, 669–670. [Google Scholar] [CrossRef] [PubMed]
- Cunha, B.A.; Burillo, A.; Bouza, E. Légionnaires’ disease. Lancet 2016, 387, 376–385. [Google Scholar] [CrossRef]
- Hamilton, K.A.; Haas, C.N. Critical review of mathematical approaches for quantitative microbial risk assessment (QMRA) of Legionella in engineered water systems: Research gaps and a new framework. Environ. Sci. Water Res. Technol. 2016, 2, 599–613. [Google Scholar] [CrossRef]
- Bentham, R.; Whiley, H. Quantitative microbial risk assessment and opportunist waterborne infections–are there too many gaps to fill? Int. J. Environ. Res. Public Health 2018, 15, 1150. [Google Scholar] [CrossRef] [PubMed]
- Kenagy, E.; Priest, P.C.; Cameron, C.M.; Smith, D.; Scott, P.; Cho, V.; Mitchell, P.; Murdoch, D.R. Risk factors for Legionella longbeachae legionnaires’ disease, New Zealand. Emerg. Infect. Dis. 2017, 23, 1148. [Google Scholar] [CrossRef]

| Species | Number in 2020 | Percent of Cases |
|---|---|---|
| L. pneumphila | 1087 | 95.9 |
| L. anisa | 2 | 0.2 |
| L. bozemanii | 4 | 0.4 |
| L. longbeachae | 22 | 1.9 |
| L. micdadei | 3 | 0.3 |
| L. cincinnatiensis | 1 | 0.08 |
| L. species unknown | 14 | 1.2 |
| Bartrand et al. [53] | Omoregie et al. [49] | Wang et al. [54] | |
|---|---|---|---|
| Samples analyzed | 143 | 544 or 528 1 | 56 |
| Legiolert (L. pneumophila) positive samples (%) | 0.7% | 2.2% | ND |
| ISO method (L. pneumophila) positive samples (%) | 0% | 1.1% | 1.8% |
| viability qPCR/qPCR (L. pneumophila) positive samples (%) | 1.4% | 0.95% | 5.6% |
| Legionella spp. positive samples by v-qPCR 2 or qPCR 3 (%) | 37% 2 | 84.8% 3 | 86.3% 3 |
Disclaimer/Publisher’s Note: The statements, opinions and data contained in all publications are solely those of the individual author(s) and contributor(s) and not of MDPI and/or the editor(s). MDPI and/or the editor(s) disclaim responsibility for any injury to people or property resulting from any ideas, methods, instructions or products referred to in the content. |
© 2025 by the author. Licensee MDPI, Basel, Switzerland. This article is an open access article distributed under the terms and conditions of the Creative Commons Attribution (CC BY) license (https://creativecommons.org/licenses/by/4.0/).
Share and Cite
LeChevallier, M.W. The Case for Monitoring for Legionella pneumophila in Drinking Water Distribution Systems. Water 2025, 17, 475. https://doi.org/10.3390/w17040475
LeChevallier MW. The Case for Monitoring for Legionella pneumophila in Drinking Water Distribution Systems. Water. 2025; 17(4):475. https://doi.org/10.3390/w17040475
Chicago/Turabian StyleLeChevallier, Mark W. 2025. "The Case for Monitoring for Legionella pneumophila in Drinking Water Distribution Systems" Water 17, no. 4: 475. https://doi.org/10.3390/w17040475
APA StyleLeChevallier, M. W. (2025). The Case for Monitoring for Legionella pneumophila in Drinking Water Distribution Systems. Water, 17(4), 475. https://doi.org/10.3390/w17040475






